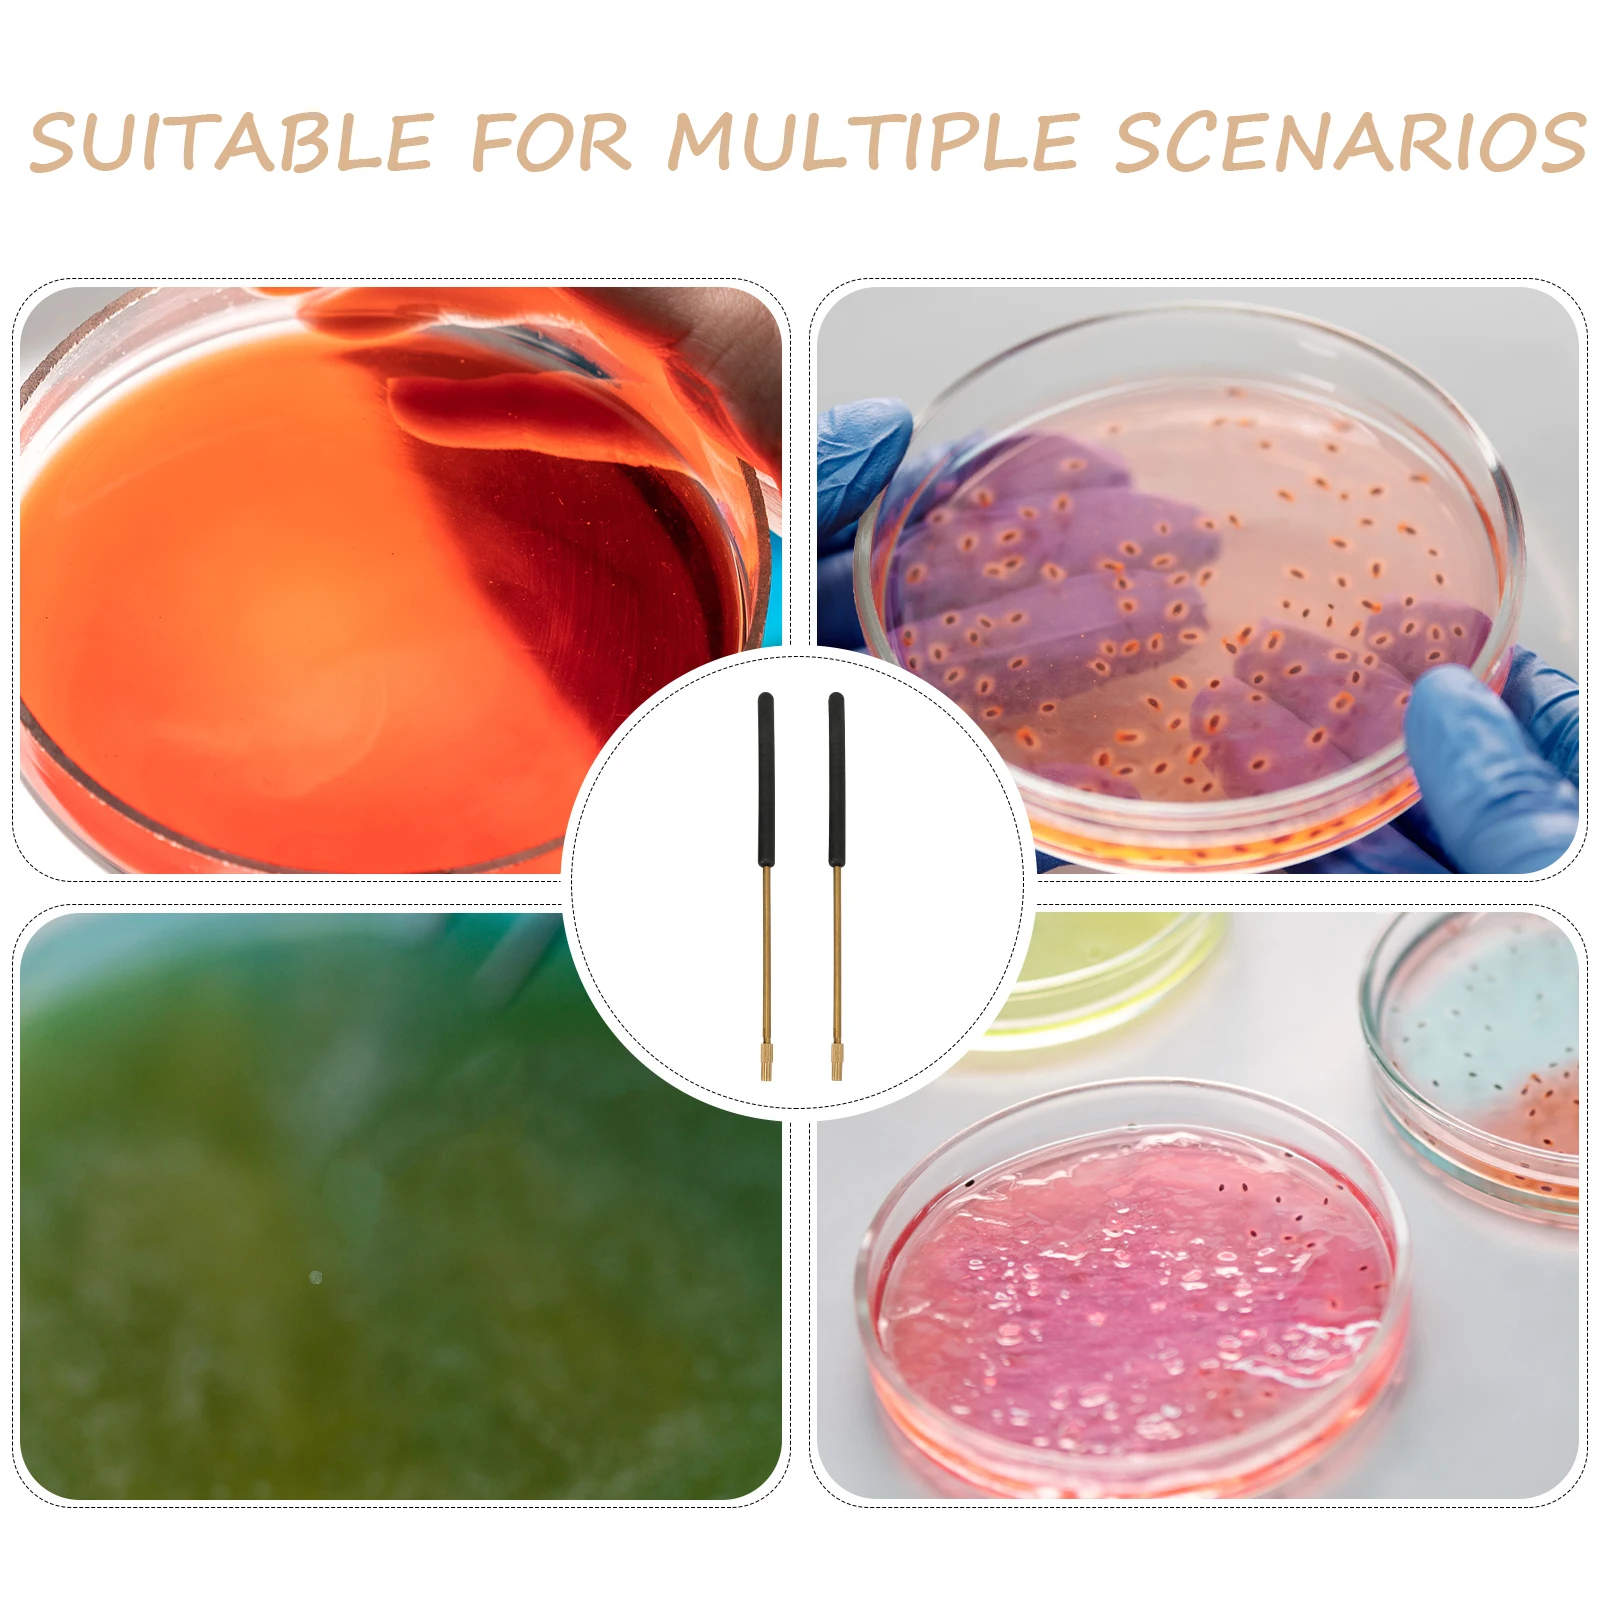

Новая задняя крышка для ноутбука ASUS ROG G751 G751J G751JY, передняя панель, Упор для рук, Нижняя крышка A B C D, верхняя крышка
Price history chart & currency exchange rate
Customers also viewed

$3.34
Digital Meat Thermometer Food Cooking Waterproof Instant Read Meat Temp Guide Kitchen Gadgets Pink
aliexpress.com
$67.15
Световой меч ZK50, 110 см, RGB, высокое качество, новый звук, световой меч, меч, металлический материал, игрушка для косплея, подарок на день рождения
aliexpress.ru
$14.37
Роботизированный пылесос с низким уровнем шума для уборки пола, пылеуловитель ковров, белый
aliexpress.ru
$1,486.84
AI-8C Core Alignment 6motors волоконно-оптическая сращивающая машина, устройство для термического сращивания для телекоммуникационной основной сети
aliexpress.ru
$9.47
Decor Desktop Ornament Mold Plaster Molds Epoxy Resin White Cast Crafting Women Woman
aliexpress.ru
$11.62
Home Decoration Supplies Halloween Floating Fireball Party Props Glow In The Dark Party Decoration Christmas Lights
aliexpress.ru
$37.59
Женское шерстяное пальто в стиле ретро, новое модное приталенное короткое пальто высокого качества, зимнее пальто для женщин, шерстяное пальто и смешанные куртки
aliexpress.ru
$14.88
Однотонные футболки в стиле Харадзюку С буквенным принтом, уличная одежда, повседневные свободные футболки с коротким рукавом, мужская и же...
aliexpress.ru
$12.88
Новинка 2023, аниме ваше имя, 23 см, Tachibana Taki & Miyamizu Mitsuha, фигурка, периферийные предметы, искусственная кукла, коллекционные игрушки, подарки
aliexpress.ru
$18.99
Mini Pci-E к двойному Pci Express X1 в двойную фотографию высокоэффективный адаптер преобразователь для настольного ПК Asm1083 чип
aliexpress.ru
$16.10
Фоторезак для плазмы, фоторезак, фоторезак 52582, резьба 1,0, фоторезак, фоторезак для плазмы, фоторезак мм
aliexpress.ru
$2.65
Форма для посуды из смолы «сделай сам», Овальная Круглая силиконовая форма, форма для пластины, форма для поделок из смолы
aliexpress.ru
$85.06
Роскошные брендовые дизайнерские женские ботильоны из натуральной кожи, новые массивные ботинки на платформе, женские ботинки в стиле панк, модная женская обувь
aliexpress.ru
$5.06
Обложка для паспорта из искусственной кожи для мужчин и женщин, дорожный Держатель для паспорта с Отделом для кредитных карт, искусственный кошелек, защитная обложка
aliexpress.ru
$2.05
1 шт., Парикмахерская бритва с Мужская кисть для бритья щетиной кабана, с черной полимерной ручкой, классический подарок
aliexpress.ru
$3.05
4 шт. металлический 3D принтер с ручной поворотной насадкой, Выравнивающая гайка 60 мм M4 для Creality Ender 3 V2/3/3 Pro, Ender 5/5 Plus/Pro, Φ/10S
aliexpress.ru
$3.16
Щетка для мытья посуды с ручкой, не жирный горшок для мытья посуды, длинная ручка, для очистки кухни
aliexpress.ru$61.99
Womens M&S Collection Fair Isle Crew Neck Relaxed Fit Jumper - Light Natural, Light Natural
marksandspencer.com![Смартфон Xiaomi Redmi Note 11S 5G 4/64Gb Midnight Black (Android 11.0, Dimensity 810, 6.6", 4096Mb/64Gb 5G ) [6934177783012]
Смартфон Xiaomi Redmi Note 11S 5G 4/64Gb Midnight Black (Android 11.0, Dimensity 810, 6.6", 4096Mb/64Gb 5G ) [6934177783012]](http://www.notik.ru/img/catalog/96411/1_xiaomiredmiredmi_note_11s_5g2203116bg.jpg)
$198.97
Смартфон Xiaomi Redmi Note 11S 5G 4/64Gb Midnight Black (Android 11.0, Dimensity 810, 6.6", 4096Mb/64Gb 5G ) [6934177783012]
notik.ru
$85.96
mens jackets down jacket with letter highly quality winter coats sports parkas clothings, Black
dhgate.com
$15.35
new gold chain hip hop pendant necklace men women fashion brand gun shape pistol pendant necklace hiphop jewelry7069839, Silver
dhgate.com
$18.15
summer holiday style flower pattern halterneck dress women casual dresses, Black;gray
dhgate.com
$44.45
women's blouses & shirts sunscreen all-match casual fashion brief outwear new stylish summer chic solid loose oversiz, White
dhgate.com
$10.17
12/24 Color Acrylic Paint Set for Canvas Wood Clay Fabric Nail Art Ceramic Craft 12Ml DF
aliexpress.com
$3.80
Men Outdoor Hiking Camping Shoulder Bag Army Hunting Fishing Bottle Pack Chest Sling Molle Backpack Military Tactical Sling Bag, Black, military green, khaki, cp camouflage, acu camouflage
alibaba.com
$61.90
women's autumn and winter plus size loose light cooked wind mid-length over-the-knee long-sleeved woolen long skirt knitted dress
fordeal.com
$41.17
evening bags trendy bag women fashion korean version of leopard print wild color contrast tote large capacity shoulder wholesale
dhgate.com
$2.96
European Popular Twisted Circle Earrings Simple Polished 18k Gold plated Stainless Steel Twist Round Hoop Earrings
alibaba.com
$52.71
Сверхлегкая оправа для очков из титанового сплава, деловая мужская оправа в стиле ретро с двойным лучом 81085, оптическая оправа с защитой от синего света
aliexpress.ru
$18.26
1 комплект ролика захвата бумаги для Xerox 4110 4127 4112 D95 D110 D125, ролик захвата подачи документов
aliexpress.ru
$15.16
40 мм вилка для мотоцикла, красные резиновые сапоги, универсальная Пылезащитная куртка, чехол для велосипеда
aliexpress.ru
$13.60
Стельки для акупрессуры для мужчин и женщин — ортопедические стельки для акупунктурного массажа с амортизацией, нескользящие ноги и поддержкой свода стопы
aliexpress.ru
$1.78
2pcs Pure Copper Inoculating Rod Microbiology Lab Tool Inoculation Loop For Agar Culture Medium Experiments
aliexpress.ru
$83.65
PPF Paint Protection Film for Volvo S90 2017 2018 2019 2024 Precut Car Clear Kit Bra Transparent PPF TPU 8.5mil Sticker
aliexpress.ru